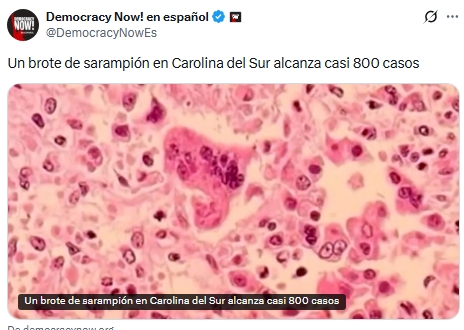

Noticias Nacionales Enero 30 viernes
Caricaturas Nacionales Enero 30 viernes
Clima Nacional Enero 30 viernes
Tráfico Nacional Enero 30 viernes
Si le interesa la información de ayer , puede ingresar a Noticias Internacionales Enero 29, jueves
Departamento de Justicia niega haber ocultado información sobre Trump en archivos del caso Epstein
El fiscal general adjunto de Estados Unidos, Todd Blanche, aseguró que el Departamento de Justicia (DOJ) no ocultó información relacionada con el presidente Donald Trump en la reciente publicación masiva de documentos vinculados al caso del fallecido delincuente sexual Jeffrey Epstein.
Durante una rueda de prensa, Blanche afirmó que el DOJ cumplió plenamente con la ley y que no se protegió a ninguna persona en la divulgación de los archivos. “No protegimos al presidente Trump. No protegimos, ni dejamos de proteger a nadie”, declaró, en respuesta a cuestionamientos sobre si todos los documentos relevantes habían sido liberados.
Las declaraciones se producen en medio del escrutinio público generado por la difusión de un nuevo paquete de archivos judiciales relacionados con el caso Epstein, que ha involucrado a diversas figuras públicas.
Fallece la legendaria actriz Catherine O’Hara a los 71 años
La actriz canadiense Catherine O’Hara, conocida por icónicos papeles en Schitt’s Creek, Home Alone (“Mi pobre angelito”) y Beetlejuice, falleció este viernes a los 71 años, informaron medios estadounidenses como TMZ y People.
O’Hara era una figura destacada en cine y televisión, ganadora de premios como el Emmy por su papel de Moira Rose en Schitt’s Creek. Aunque se desconoce la causa oficial de su muerte, se reporta que fue trasladada de urgencia a un hospital en Los Ángeles en estado grave antes de fallecer.
Su carrera abarcará décadas de trabajos memorables en comedia y actuación, dejando un legado influyente en la cultura popular.

12:19 pm
Fuente: Transdoc
Cuba declara “emergencia internacional” tras aranceles de EE. UU. a países que envíen petróleo a la isla
El Gobierno de Cuba declaró una “emergencia internacional” en respuesta a la decisión del presidente de Estados Unidos, Donald Trump, de imponer aranceles a los países que suministren petróleo a la isla, una medida que La Habana considera una amenaza directa a su estabilidad económica y energética.
El canciller cubano, Bruno Rodríguez, afirmó en la red social X que el pueblo cubano, con apoyo de la comunidad internacional, concluye que la política del Gobierno estadounidense constituye una “amenaza inusual y extraordinaria”, atribuida según sus palabras a sectores de la derecha neofascista anticubana en Estados Unidos.
La declaración eleva el tono diplomático entre ambos países y busca alertar a la comunidad internacional sobre el impacto que estas sanciones podrían tener en el acceso de Cuba a combustibles y servicios básicos.
Berlín lanza su campaña para postularse como sede de futuros Juegos Olímpicos
La ciudad de Berlín presentó este viernes su campaña oficial para convertirse en la candidata alemana a albergar futuros Juegos Olímpicos, con un enfoque centrado en el desarrollo urbano y deportivo para las generaciones jóvenes y futuras.
Bajo el lema “Berlín gana con las Olimpíadas”, la iniciativa fue lanzada en el velódromo de la capital alemana, en un acto que contó con la participación de 150 niños. El alcalde Kai Wegner destacó que el objetivo no es solo mejorar la infraestructura deportiva, sino impulsar inversiones estratégicas para el futuro de la ciudad.
La Confederación Alemana de Deportes Olímpicos decidirá el próximo 26 de septiembre qué ciudad representará a Alemania y para qué edición de los Juegos: 2036, 2040 o 2044. Además de Berlín, compiten Múnich, Hamburgo y la región del Rin-Ruhr.
Israel reabrirá el cruce de Rafah entre Egipto y Gaza a partir del 1 de febrero
El Gobierno de Israel anunció que el cruce de Rafah, que conecta Egipto con la Franja de Gaza y se encuentra bajo control militar israelí, será reabierto el próximo domingo 1 de febrero para la entrada y salida limitada de personas.
Según informó el Gogat, organismo militar encargado de asuntos civiles en los territorios palestinos ocupados, la reapertura se realizará conforme a los términos del alto el fuego. El paso fronterizo operará en coordinación con Egipto, bajo autorización de seguridad de Israel y con supervisión de una misión de la Unión Europea, siguiendo un mecanismo similar al aplicado en enero de 2025. El cruce permanecía bajo control israelí desde la ofensiva en el sur de Gaza en mayo de 2024.
.jpeg)
Reino Unido libera anticipadamente a casi 49.000 presos para aliviar el hacinamiento carcelario
Un total de 48.931 presos fueron liberados de forma anticipada en el Reino Unido entre el 10 de septiembre de 2024 y el 30 de septiembre de 2025, como parte de un plan de emergencia para reducir el hacinamiento en las cárceles, según cifras del Ministerio de Justicia británico difundidas este jueves por medios locales.
La medida se aplicó a través de un programa de liberación anticipada de emergencia impulsado por el Gobierno laborista, que entró en vigor poco después de que la población penitenciaria alcanzara un récord histórico de 88.521 internos.
Brote de sarampión en Carolina del Sur se convierte en el más grande en EE. UU. en más de 20 años
El brote de sarampión en Carolina del Sur se ha convertido en el más grande registrado en Estados Unidos desde que la enfermedad fue declarada eliminada hace más de dos décadas, según informó el Centro de Investigación y Política de Enfermedades Infecciosas (CIDRAP) de la Universidad de Minnesota.
Con 789 casos confirmados, el brote ya superó al de Texas en 2025, que había sido el mayor hasta ahora y que dejó dos muertes infantiles. Actualmente, 557 personas permanecen en cuarentena en el estado por posible exposición al virus, al no contar con inmunidad previa ni vacunación.
10:17 am
Fuente: Transdoc
Rusia confirma una tregua energética con Ucrania hasta el 1 de febrero
Rusia acordó abstenerse de realizar ataques contra Ucrania hasta el 1 de febrero, tras una solicitud directa del presidente de Estados Unidos, Donald Trump, con el objetivo de crear condiciones favorables para las negociaciones, informó el portavoz del Kremlin, Dmitri Peskov.
Según explicó Peskov a la prensa, Trump pidió personalmente al presidente Vladímir Putin que evitara ataques, incluida la capital Kiev, durante una semana. El portavoz confirmó que el Kremlin aceptó la propuesta, en lo que se interpreta como un gesto temporal para facilitar un posible proceso de diálogo diplomático.

09:52 am
Fuente: Transdoc
Descubren un planeta potencialmente habitable similar a la Tierra a 150 años luz
Un equipo internacional de científicos identificó un planeta potencialmente habitable ubicado a 150 años luz de la Tierra, con un tamaño muy parecido al de nuestro planeta, informó la Universidad del Sur de Queensland (Australia). El hallazgo fue publicado en la revista The Astrophysical Journal Letters.
El planeta, denominado HD 137010 b, es apenas un 6 % más grande que la Tierra y presenta una temperatura superficial comparable a la de Marte, que podría ser inferior a los -70 °C. Fue descubierto gracias a datos de la misión extendida K2 del telescopio espacial Kepler de la NASA, recopilados en 2017.
Los investigadores determinaron que el planeta se encuentra cerca del límite exterior de la zona habitable, donde podría existir agua líquida en su superficie. Además, su estrella anfitriona es similar al Sol, lo que aumenta la posibilidad de que el planeta conserve una atmósfera.
Según el autor principal del estudio, Alexander Venner, se trata del primer candidato con características similares a la Tierra orbitando una estrella lo suficientemente brillante como para permitir observaciones de seguimiento, lo que lo convierte en un objetivo clave para futuras investigaciones.
Colombia reanuda vuelos de repatriación desde EE. UU. antes de reunión Petro-Trump
El Gobierno de Colombia anunció la reanudación de los vuelos de repatriación de ciudadanos colombianos deportados desde Estados Unidos, pocos días antes del encuentro que sostendrán la próxima semana en la Casa Blanca los presidentes Gustavo Petro y Donald Trump.
La Cancillería informó que la medida se adopta como parte del compromiso con un trato digno a los connacionales y se realiza en coordinación con la Fuerza Aérea Colombiana. El anuncio fue difundido a través de la cuenta oficial del Ministerio de Relaciones Exteriores en la red social X.
09:16 am
Fuente: Transdoc
Sindicato alemán convoca huelga nacional del transporte público por mejores condiciones laborales
El sindicato alemán de servicios ver.di convocó a casi 100.000 trabajadores del transporte público municipal a una huelga nacional en Alemania el próximo lunes 2 de febrero de 2026, con el objetivo de exigir mejores condiciones laborales.
La vicepresidenta del sindicato, Christine Behle, señaló que los empleados enfrentan una alta carga de trabajo debido a horarios desfavorables, turnos rotativos y una constante presión de tiempo. Ver.di reclama mejoras urgentes para frenar la elevada rotación de personal y atraer trabajadores cualificados. El sindicato criticó además que, durante las negociaciones en los 16 estados federados, las asociaciones patronales municipales se han negado a la mayoría de las demandas e incluso han planteado aumentar la carga laboral.
08:51 am
Fuente: Transdoc
Costa Rica entra en periodo de reflexión previo a las elecciones generales del 1 de febrero
Este jueves sr cerró la campaña electoral en un ambiente festivo, marcado por actividades públicas y el último debate presidencial en el que participaron Claudia Dobles, Álvaro Ramos, Ariel Robles, Juan Carlos Hidalgo y José Aguilar, quienes centraron sus propuestas en el combate a la corrupción, el fortalecimiento de la educación y medidas contra la inseguridad.
Con el cierre de campaña, el país entra ahora en el periodo de reflexión del voto previo a los comicios..jpeg)
08:36 am
Fuente: Transdoc
EE.UU. retirará certificación a aviones canadienses
El presidente de Estados Unidos, Donald Trump, anunció que los jets Bombardier y otras aeronaves fabricadas en Canadá perderán su certificación para operar en Estados Unidos, hasta que Canadá autorice la certificación de los aviones Gulfstream, de origen estadounidense.
El anuncio fue realizado a través de su plataforma Truth Social, en lo que representa un nuevo episodio de tensión comercial entre Washington y Ottawa. Trump aseguró que la descertificación se mantendrá hasta que Gulfstream sea aprobada “como debió ocurrir hace muchos años”.
Además, el mandatario advirtió que impondrá un arancel del 50 % a los aviones canadienses vendidos en Estados Unidos si Canadá continúa bloqueando la comercialización de los productos de Gulfstream. La medida podría afectar seriamente a la industria aeronáutica canadiense y agravar el conflicto bilateral.
.jpeg)
Kevin Warsh es nominado como presidente de la Reserva Federal
El presidente de Estados Unidos, Donald Trump, anunció la nominación del banquero y economista Kevin Warsh como próximo presidente de la Junta de Gobernadores de la Reserva Federal, en sustitución de Jerome Powell.
El anuncio fue realizado a través de la red Truth Social, donde Trump elogió ampliamente la trayectoria de Warsh y aseguró que “tiene el perfil perfecto” para liderar el banco central estadounidense. El mandatario afirmó que no duda de que Warsh “pasará a la historia como uno de los grandes presidentes de la Fed”.
Trump destacó que Warsh fue nombrado en 2006, a los 35 años, como el gobernador más joven en la historia de la Reserva Federal, cargo que ocupó hasta 2011. Además, recordó su experiencia como asesor económico del expresidente George W. Bush y su actual vínculo con el Hoover Institution, uno de los centros de pensamiento conservadores más influyentes de California.
.jpeg)
Trump lanza iniciativa nacional para combatir la adicción a las drogas en EE. UU.
El presidente de Estados Unidos, Donald Trump, firmó este jueves un decreto que pone en marcha La Gran Iniciativa de Recuperación Estadounidense, un programa gubernamental destinado a combatir la adicción a las drogas mediante la coordinación de recursos federales, estatales, locales y del sector privado.
El plan busca fortalecer la prevención, el tratamiento y la recuperación de personas con adicciones, movilizando toda la capacidad del Gobierno federal. Durante el anuncio en la Oficina Oval, acompañado por el secretario de Salud y Servicios Humanos, Robert F. Kennedy Jr., Trump destacó la gravedad del problema. 
07:47 am
Fuente: Transdoc
El CNE de Venezuela suspende temporalmente el inicio del registro de nuevas organizaciones políticas
El Consejo Nacional Electoral (CNE) de Venezuela aprobó una resolución que suspende de manera temporal la convocatoria para la creación, inscripción y registro de nuevas organizaciones políticas en el país.
La medida, adoptada en sesión el 28 de enero y publicada en los canales oficiales del organismo, aplaza la publicación del aviso anual que abre legalmente este proceso, sin el cual no puede iniciarse la presentación de solicitudes de denominación provisional, paso inicial para formar partidos políticos.
El CNE explicó que tomó la decisión con base en sus atribuciones constitucionales y electorales para “ordenar y racionalizar procedimientos”, aunque no especificó un plazo para reanudar el proceso ni detalló las circunstancias excepcionales que motivaron la suspensión.
Nueva Zelanda rechaza unirse a la Junta de Paz impulsada por Donald Trump
Nueva Zelanda anunció este viernes 30 de enero de 2026 que no formará parte de la Junta de Paz creada por el presidente de Estados Unidos, Donald Trump, sumándose a un reducido grupo de países que han declinado la invitación.
El canciller Winston Peters explicó que, en su forma actual, la participación de Nueva Zelanda no aportaría un valor añadido significativo, especialmente considerando que otros países de la región ya se han comprometido a colaborar, particularmente en Gaza. No obstante, Wellington aclaró que seguirá de cerca la evolución de la iniciativa y reiteró su firme compromiso con el rol central de las Naciones Unidas en los procesos de paz internacionales.

Argentina declara emergencia en cuatro provincias de la Patagonia por incendios forestales
El gobierno de Argentina anunció este jueves 29 de enero de 2026 que decretará una emergencia ígnea en cuatro provincias de la Patagonia Chubut, Río Negro, Neuquén y La Pampa debido a los incendios forestales que desde el inicio del verano austral han arrasado decenas de miles de hectáreas.
La situación más crítica se vive en Chubut, donde al menos 45.000 hectáreas de bosque ya fueron consumidas por el fuego. Cientos de brigadistas continúan trabajando para evitar que las llamas lleguen a zonas pobladas, aprovechando una leve mejora climática tras recientes lluvias. La medida, anunciada por el jefe de gabinete Manuel Adorni, responde a pedidos de los gobernadores patagónicos ante la gravedad de la situación.
El Senado de EE. UU. alcanza un acuerdo para evitar el cierre del gobierno
El Senado de Estados Unidos logró un acuerdo para evitar el cierre del gobierno federal, que se temía pudiera ocurrir a partir de la medianoche del viernes.
El presidente Donald Trump anunció que republicanos y demócratas consensuaron financiar la mayor parte del gobierno hasta septiembre y otorgar una prórroga temporal al Departamento de Seguridad Nacional (DHS).
El pacto contempla separar el financiamiento del DHS del resto de los proyectos presupuestarios y asignarle recursos por dos semanas, mientras se discuten las demandas demócratas para limitar la actividad del Servicio de Inmigración y Control de Aduanas (ICE). Se espera que la votación se realice en las próximas horas.




.png)





